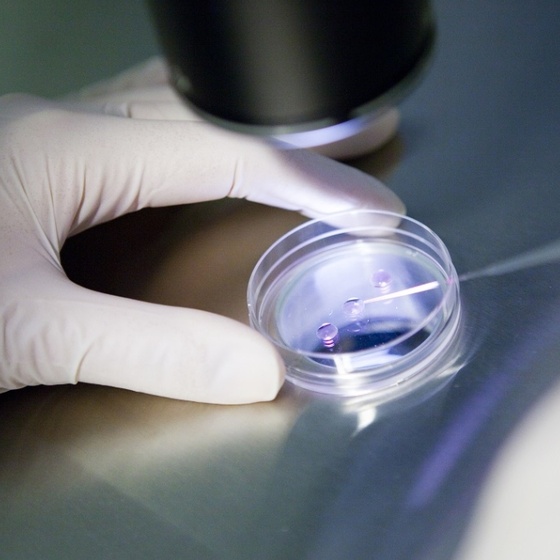
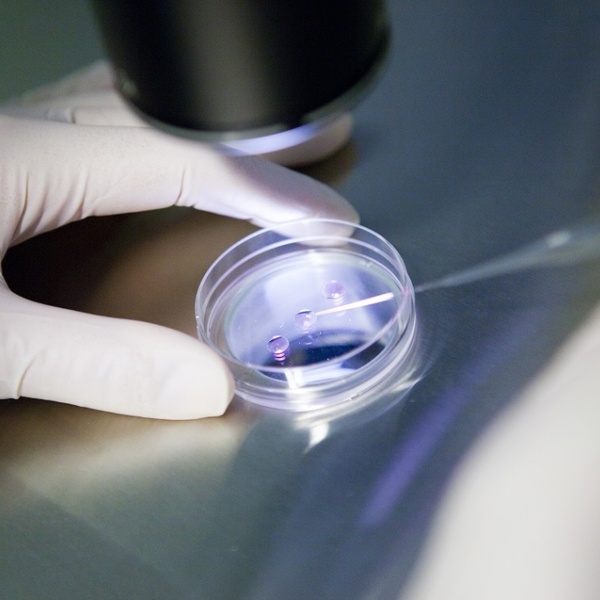

Пн-Пт: 8.00 - 20.00, Сб: 9.00 - 13.00





Пн-Пт: 8.00 - 20.00, Сб: 9.00 - 13.00
Репродуктология
- Бесплодие
- Невынашивание
- Привычное невынашивание
- Эндометриоидная болезнь
- Непроходимость маточных труб
- Большие кисты яичников
- Миомы матки, которые деформируют ее полость
- Варикоцеле
- Гидроцеле
- Крипторхизм
- Аномалии развития половых органов
- Искусственное оплодотворение (ЭКО)
- Внутриматочная инсеминация (ВМИ)
Консервативное и хирургическое лечение
Диагностика и лечение
Вспомогательные репродуктивные технологии

Оставить заявку
на бесплатную консультацию
на бесплатную консультацию
Вы можете прикрепить медицинские документы. Подойдут электронные копии или фото имеющихся документов: выписной эпикриз, выписка из истории болезни, результаты обследований, УЗИ, снимки МРТ или рентгенографии
Нажимая на кнопку, Вы даете согласие на обработку персональных данных
Если у вас много документов, лучше отправить их на электронную почту:
zamed.kz@mail.ru
Остались вопросы?
Пишите или звоните
Наш телефон:
Мы в соцсетях:




Быстрая связь:



